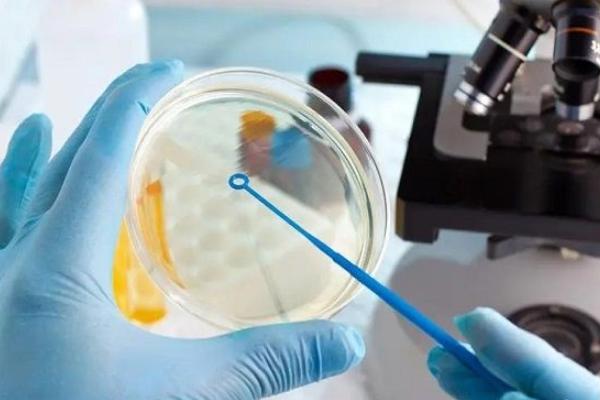
2022年东莞哪些医院能做试管?东莞试管医院排名揭晓?

时间:2023-10-26 分类: 试管资讯 查看: 49
2022年东莞哪些医院能做试管?东莞试管医院排名揭晓?东莞市医疗科技发达,试管医院也比较多,到目前为止,东莞有试管技术资质的医院就有六家,其中,大部分的医院都支持夫精人工授精技术、常规助孕怀孕-胚胎移植技术、卵胞浆内单三代试管生子显微注射技术,但是,很多家庭还是不太了解,如何选择试管医院,也不知道东莞有哪些医院能做试管,接下来为大家揭晓东莞的试管医院排名,并介绍几家口碑比较好的试管医院供大家参考。
东莞有6家医院可以进行人工授精,首位代和第二代试管技术,患者可以根据自己的情况或就近选择医院。
| 序号 | 医院名称 | 能否做试管 | 医院地址 |
| 1 | 东莞市试管医院 | 能做 | 东莞市东城区光明大道明新街2号 |
| 2 | 东莞广济医院 | 能做 | 广东省东莞市凤岗镇雁田镇田北路1号 |
| 3 | 东莞康华医院 | 能做 | 广东省东莞市东莞大道1000号 |
| 4 | 东莞试管医院 | 能做 | 东莞市东莞市旗峰路178号 |
| 5 | 东莞试管医院 | 能做 | 东莞市石龙镇黄洲区祥龙路1号 |
| 6 | 东莞市试管医院 | 能做 | 东莞市东城区主山社区振兴路99号 |
| 7 | 东莞桥头医院 | 不能做 | 广东省东莞市桥头镇工业路43号 |
| 8 | 东莞市第八试管医院 | 不能做 | 东莞市石龙镇西湖三路68号博爱园 |
| 9 | 东莞试管医院湾试管医院 | 不能做 | 东莞虎门镇运河北路124号 |
| 10 | 东莞市试管医院 | 不能做 | 东莞市东门路61号 |
上表是东莞试管医院的医院排名,与医院的综合实力无关,仅以辅助生殖准入时间为序。目前,东莞还没有医院可以做第三代试管婴儿。想做第三代试管的可以去广东省其他医院,比如广东试管医院、试管医院市第试管医院院、广州市第试管医院。
东莞有很多医院可以做试管。选择试管成功率高的医院是不孕家庭非常重要的参考。为了方便更多姐妹选择合适的医院,我们推荐东莞几家口碑比较好的试管医院,助孕括医院简介、单周期试管婴儿费用和成功率的介绍
东莞市试管医院

| 试管医院介绍 |
|
东莞市试管医院科是医院开展的重点科室。2013年获得助孕怀孕胚胎移植及相关衍生技术资格。目前,该部门IVF妊娠率可达50%,与国内大型试管医院妊娠率相同,试管费用不贵,约2.5-6万元左右。
2.东莞市试管医院

| 试管医院介绍 |
|
东莞市三代试管医院是广东试管医院保健协会生殖保健分会常委单位和东莞市试管医院分会主委单位。医疗技术护理团队30人。其主要技术骨干均通过国家技术培训,取得资格证书,承担全市生殖健康技术继续教育任务婴儿成功率不低,可保持在45%左右。
东莞试管医院

| 试管医院介绍 |
|
东莞试管医院是一家现代化的综合性医院。该医院试管医院科成立于2013年。所有科室人员均经国家卫生部门培训,符合试管医院专业要求。试管医院科的诊断和治疗范围助孕括男性少弱畸精、性交障碍、输卵管不孕、排卵功能障碍等。
小提示:2022年东莞哪些医院能做试管?东莞试管医院排名揭晓?以上便是2022年东莞哪些医院能做试管?东莞试管医院排名揭晓?的全部内容,想了解更多试管医院成功率等问题,请咨询求医网试管频道的专业助孕顾问!